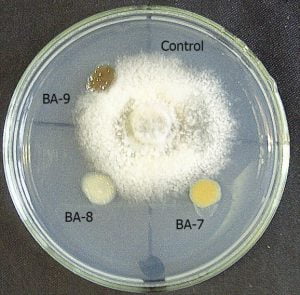

bentonite7
Từ khóa
Tin liên quan
- Vai trò của nucleotide trong dinh dưỡng chức năng – Cải thiện tăng trưởng và khả năng chống chịu dịch bệnh cho vật nuôi với nucleotide tinh khiết
- Nguy cơ thuốc thú y và thức ăn bổ sung thuộc phân loại hàng hóa rủi ro cao
- AAAP 2026: Thông báo mở đăng ký và nộp bài
- Kiểm tra công tác tiêm phòng dại chó, mèo tại xã Thư Lâm
- Xuất khẩu thịt lợn của Brazil 3 tháng đầu năm 2026 tăng 16,5%
- Xuất khẩu thức ăn gia súc sang các thị trường 3 tháng đầu năm 2026
- Cập nhật dinh dưỡng axit amin cho gà thịt
- Hội Chăn nuôi Việt Nam: 35 năm đồng hành cùng sự phát triển của ngành chăn nuôi
- Giải bài toán chi phí chăn nuôi bằng sức mạnh logistics quy mô lớn
- Giá sản phẩm chăn nuôi (giá tại trại) cả nước ngày 14/04/2026
Tin mới nhất
T5,16/04/2026
- Vai trò của nucleotide trong dinh dưỡng chức năng – Cải thiện tăng trưởng và khả năng chống chịu dịch bệnh cho vật nuôi với nucleotide tinh khiết
- AAAP 2026: Thông báo mở đăng ký và nộp bài
- Kiểm tra công tác tiêm phòng dại chó, mèo tại xã Thư Lâm
- Xuất khẩu thịt lợn của Brazil 3 tháng đầu năm 2026 tăng 16,5%
- Xuất khẩu thức ăn gia súc sang các thị trường 3 tháng đầu năm 2026
- Cập nhật dinh dưỡng axit amin cho gà thịt
- Hội Chăn nuôi Việt Nam: 35 năm đồng hành cùng sự phát triển của ngành chăn nuôi
- Giải bài toán chi phí chăn nuôi bằng sức mạnh logistics quy mô lớn
- Giá sản phẩm chăn nuôi (giá tại trại) cả nước ngày 14/04/2026
- Bộ Nông nghiệp và Môi trường dự kiến phân quyền, phân cấp 44 thủ tục hành chính cho địa phương
- AChaupharm: Nấm phổi gia cầm, hiểm họa thầm lặng khi giao mùa
- Chuyên gia bàn giải pháp sử dụng kháng sinh có kiểm soát trong chăn nuôi
- Ngành sữa Việt Nam: Cơ hội “bứt phá” từ nội lực
- Dịch tả heo châu Phi: Hiện trạng và giải pháp kiểm soát hiệu quả (Phần 1)
- Bộ NN&MT mở đợt ‘truy quét’ việc lạm dụng chất kích tăng trưởng, tăng trọng
- Cargill rút khỏi ngành thức ăn thủy sản tại Việt Nam, đóng cửa nhà máy tại Đồng Tháp và Long An
- Chăn nuôi dê bền vững theo chuỗi giá trị: Chủ nhà hàng là mắt xích quan trọng
- Da khỏe, lông đẹp: Chiến lược dinh dưỡng hiệu quả cho heo con sau cai sữa
- Lo ngại bệnh than, Campuchia ngừng nhập một số sản phẩm từ Thái Lan
- Cạn tiền, một công ty tại Nam Phi phải tiêu hủy hơn 350.000 con gà

Bình luận mới nhất